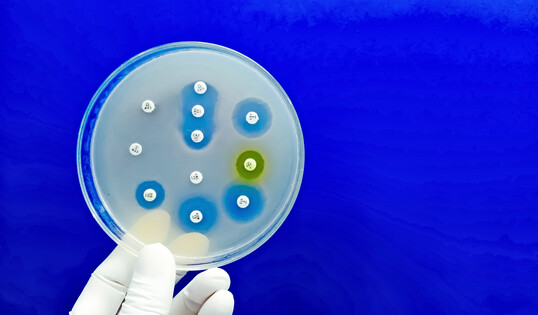
Test auf Antibiotikaresistenzen in einer Petrischale.

Zwischen Verbraucherschutz und Wettbewerbsdruck
Antibiotikaeinsatz in der Tierhaltung sorgt für Streit: Verbraucherschützer warnen vor Resistenzrisiken, während Tierärzte und Landwirte Wettbewerbsnachteile befürchten.
von DGS Redaktion Quelle lebensmittelpraxis.de erschienen am 20.11.2025Wie ein aktueller Bericht der Lebensmittel Praxis zeigt, bleibt der Einsatz von Antibiotika in der deutschen Nutztierhaltung trotz rückläufiger Mengen ein kontroverses Thema. Zwar ist der Gesamtverbrauch zwischen 2018 und 2023 um rund 27 % gesunken, doch im europäischen Vergleich liegt Deutschland weiterhin auf einem hohen Niveau. In der Geflügelmast erhalten nach Angaben der Verbraucherzentrale Niedersachsen noch immer mehr als acht von zehn Tieren Antibiotika ein Wert, der aus Sicht der Organisation ein strukturelles Problem widerspiegelt.
Die Verbraucherzentrale, vertreten durch Ernährungsexpertin Constanze Rubach, fordert deshalb strengere Vorgaben und mehr Transparenz für Konsumenten. Sie verweist auf die nach wie vor hohe Belastung mit resistenten Keimen in Fleischprodukten und warnt davor, das Gesundheitsrisiko zu unterschätzen. Gleichzeitig verweist Rubach darauf, dass Deutschland im Vergleich zu Ländern wie Schweden oder den Niederlanden deutlich mehr Antibiotika pro Tier einsetzt.
Eine andere Sicht vertritt Fachtierarzt Dr. Thorsten Pabst. Er betont, dass bereits ein engmaschiges Kontrollsystem existiert und eine weitere Verschärfung die Betriebe mit zusätzlicher Bürokratie belasten könnte. Aus seiner Sicht drohen wirtschaftliche Nachteile für die deutsche Landwirtschaft, wenn nationale Anforderungen ohne europäische Harmonisierung weiter steigen.
Für den Handel und die Lebensmittelwirtschaft ergibt sich daraus eine klare Entwicklung: Das Interesse der Verbraucher an antibiotikareduzierten Produkten wächst weiter, und die Anforderungen an Rückverfolgbarkeit, Dokumentation und Kommunikation entlang der Lieferkette steigen. Gleichzeitig müssen Produzenten und Händler die Balance zwischen Verbraucherschutz, Kostendruck und Marktpositionierung finden in einem Umfeld, in dem Regulierung und öffentliche Erwartungen spürbar anziehen.